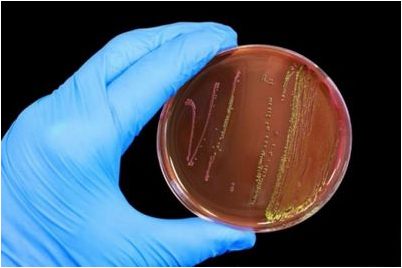
канариум филиппинский

Ядовитые микробы methylmercury-производства, более широко распространенные, чем реализованный
Это открытие, изданное в Науке об окружающей среде и Технологии, объясняет, почему смертельная methylated ртуть произведена в областях, где присутствие нейротоксина озадачивало исследователей в течение многих десятилетий. Methylmercury – самая опасная форма ртути – повреждает мозговую и иммунную систему и особенно вредна для развивающихся эмбрионов. …